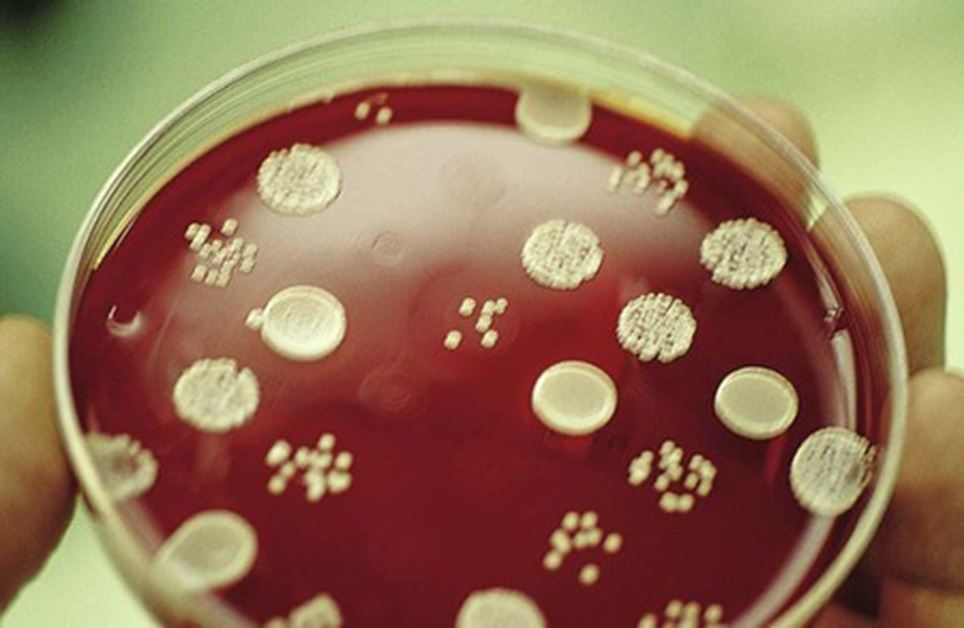

Minimum Inhibitory Concentration (MIC)
Minimum Inhibitory Concentration (MIC) is the lowest concentration (expressed as mg/L or μg/μL) of an antimicrobial agent that inhibits the visible in-vitro growth of microorganisms. The MIC test determines the antimicrobial activity of a test agent against a specific bacteria. E-test, tube dilution, and agar dilution methods are employed to determine MIC value.

While performing the dilution method, the antimicrobial’s lowest concentration (highest dilution) preventing the appearance of turbidity (growth) is considered MIC. At this dilution, the antimicrobial agent is bacteriostatic, i.e. some bacteria may still be alive.
Once the MIC is calculated, it can be compared to known values for a given bacterium and antimicrobial agentand is interpreted as **susceptible, susceptible-dose dependent (SSD), intermediate,**and **resistant.**The interpretive criteria for these categories are based on;
- extensive research that correlates MIC with serum achievable levels for each antimicrobial agent,
- particular resistance mechanisms, and
- successful therapeutic outcomes
Relationship between MIC and Zone of Inhibition
The MIC and the zone diameter of inhibition are inversely correlated. The more susceptible the microorganism is to the antimicrobial agent, the lower the MIC and the larger the zone of inhibition. Conversely, the more resistant the microorganism, the higher the MIC and the smaller the zone of inhibition.
MIC is determined only in specific clinical scenarios under the instruction of a Microbiologist, e.g.,*infective endocarditis.*MIC gives valuable information, which will help to customize the treatment to direct only the causative bacterium.
CLSI has recently recommended SDD category reporting instead of “intermediate” when reporting cefepime results for Enterobacteriaceae isolates because there are multiple approved dosing options.
Broth dilution method
The broth/tube dilution test is the standard method for determining levels of microbial resistance to an antimicrobial agent. Serial dilutions of the test agent are made in a liquid microbial growth medium inoculated with a standardized number of organisms and incubated for a prescribed time. At the end of the incubation period (generally 18-24 hours), the tubes are visually examined for turbidity.

E.g. in the image shown above, the breakpoint of growth inhibition lies between 6.25 (no turbidity is seen) and 3.12 μg/mL (turbidity is still appearing) of antimicrobial agents. However, by convention, the MIC is interpreted as the concentration of the antimicrobial agent contained in the first tube in the series that inhibits visible growth. Therefore, in this example, the MIC is 6.25 μg/mL. Find more about broth dilution method
Agar dilution method
Varying concentrations of antimicrobial agents are added to an agar medium, mostly Mueller Hinton Agar (for non-fastidious organisms). Multiple test organisms (at a concentration of 10^4 CFU/mL) can be applied directly or using an inoculum replicating apparatus (steer replicator) on a single agar plate of a particular antibiotic concentration. Results are observed after incubation at 35°C for 18-24 hours.
E-test method

A plastic strip with a predefined gradient of one antibiotic is applied onto an inoculated agar plate. After 18-24 hours of incubation, a drop-shaped inhibition zone intersects the graded test strip at the inhibitory concentration of the antibiotic.
The intersection of the lower part of the ellipse-shaped growth inhibition area with the test strip indicates the MIC value. Find more about E-test
Automated system for
MIC determination
Various commercial automated systems are available for antimicrobial susceptibility testing. Some of the automated system approved by the FDA and currently in use are;
- Vitek 2 system ((bioMérieux))
- MicroScan Walkaway (Beckman Coulter)
- BD Phoenix system (Becton Dickenson Diagnostics)
Reporting MIC results
Laboratories have to report the interpretive category (susceptible, susceptible-dose-dependent, intermediate, or resistant) to the physician with or without MIC value. Only reporting MIC value is not recommended as the physician may fail to interpret it appropriately.
Minimum Bactericidal Concentration (MBC)
Minimum bactericidal concentration (MBC) is the lowest concentration of antibiotics that kills 99.9% of the inoculum. Also termed minimum lethal concentration (MLC), the MBC of an antibacterial agent is determined by subculturing the last clear MIC tube onto the growth medium and examining for bacterial growth.
Normally, for bactericidal drugs, the MIC is very close or just one step from the MBC. In bacteriostatic drugs, there could be a little bit more distance between them.
References and further reading
- Koneman’s Color Atlas and Textbook of Diagnostic Microbiology
- Bailey & Scott’s Diagnostic Microbiology, Forbes, 11th edition